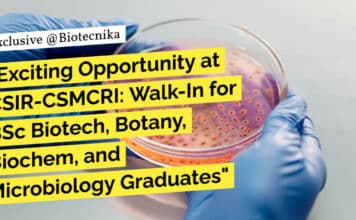
Exciting Opportunity at CSIR-CSMCRI: Walk-In for BSc Biotech, Botany, Biochem, and Microbiology Graduates "Exciting Opportunity at CSIR-CSMCRI: Walk-In for BSc Biotech, Botany, Biochem, and Microbiology Graduates"

POPULAR VIDEOS
- All
- 2X PCR MasterMix
- Abstract & Proposals
- ACTREC JRF
- Agriculture Jobs
- AI ML
- AIMGATE
- AIMNET
- Animal Biotech Jobs
- Antibodies
- ASRB NET Exam
- Awards
- B.E.
- B.Pharma
- B.Sc
- B.Tech
- BARC OCES/DGFS
- BINC Exam
- Biochemistry Jobs
- Bioinformatics Jobs
- Biological Science Job
- Biology Job
- Biomedical Engineering Job
- Biomedical Sciences Job
- Biophysics Job
- Bioprocess Engineering Jobs
- Bioreactor
- Biostatistics
- Biotech Admissions
- Biotech Internships & Projects
- Biotech Jobs
- Biotech News
- BioTecNika Magazine
- BioTecNika Times
- BioTecNika TV
- Botany Job
- BTSE
- Career Advice
- Case Studies
- Cell biology
- Cell Biology Jobs
- Cell Culture Reagent
- Cell Culture Reagents
- Cell Cultures
- Chemiluminescent HRP Substrates
- Chemistry
- Chromatography Column & Filters
- Clinical Data Management
- Clinical Research
- Compound Screening Libraries
- Computational Biology Jobs
- Computational Life Science
- Conference
- Cortisol ELISA Kits
- Course
- Courses
- CSIR NET Life Science Exam - Latest Announcements & News
- CSIR NET Life Science Notes
- CUET
- Data Science
- DBT JRF Exam
- DBT-BIITP
- Developmental Biology
- eBooks
- ELISA Kits
- Environmental Biotechnology Jobs
- Epidemiology
- Events
- Exam Alerts
- Expired
- Featured
- Fellowship
- Food Science Job
- Food Technology Jobs
- Forensic Science
- Free Downloads
- Freshers Jobs
- FSSAI Food Analyst Exam
- GAT-B
- GATE Exam
- Genetic Engineering
- Genetics Jobs
- Genomics
- Government Jobs
- Govt Job
- ICAR
- ICMR JRF
- Immunology Jobs
- Indian Forest Service Exam
- Industrial Biotechnology Jobs
- Inhibitors
- JAM
- JNU
- Jobs
- Jobs Abroad
- Jobs in Botany
- Jobs in Toxicology
- Jobs in Zoology
- Lab Supplies
- Latest Microbiology Jobs
- Life Sciences Jobs
More
MOVIE TRAILERS
Advertisement
GAMEPLAY
TRENDING NOW
TOP REVIEWS
DON'T MISS
- All
- 2X PCR MasterMix
- Abstract & Proposals
- ACTREC JRF
- Agriculture Jobs
- AI ML
- AIMGATE
- AIMNET
- Animal Biotech Jobs
- Antibodies
- ASRB NET Exam
- Awards
- B.E.
- B.Pharma
- B.Sc
- B.Tech
- BARC OCES/DGFS
- BINC Exam
- Biochemistry Jobs
- Bioinformatics Jobs
- Biological Science Job
- Biology Job
- Biomedical Engineering Job
- Biomedical Sciences Job
- Biophysics Job
- Bioprocess Engineering Jobs
- Bioreactor
- Biostatistics
- Biotech Admissions
- Biotech Internships & Projects
- Biotech Jobs
- Biotech News
- BioTecNika Magazine
- BioTecNika Times
- BioTecNika TV
- Botany Job
- BTSE
- Career Advice
- Case Studies
- Cell biology
- Cell Biology Jobs
- Cell Culture Reagent
- Cell Culture Reagents
- Cell Cultures
- Chemiluminescent HRP Substrates
- Chemistry
- Chromatography Column & Filters
- Clinical Data Management
- Clinical Research
- Compound Screening Libraries
- Computational Biology Jobs
- Computational Life Science
- Conference
- Cortisol ELISA Kits
- Course
- Courses
- CSIR NET Life Science Exam - Latest Announcements & News
- CSIR NET Life Science Notes
- CUET
- Data Science
- DBT JRF Exam
- DBT-BIITP
- Developmental Biology
- eBooks
- ELISA Kits
- Environmental Biotechnology Jobs
- Epidemiology
- Events
- Exam Alerts
- Expired
- Featured
- Fellowship
- Food Science Job
- Food Technology Jobs
- Forensic Science
- Free Downloads
- Freshers Jobs
- FSSAI Food Analyst Exam
- GAT-B
- GATE Exam
- Genetic Engineering
- Genetics Jobs
- Genomics
- Government Jobs
- Govt Job
- ICAR
- ICMR JRF
- Immunology Jobs
- Indian Forest Service Exam
- Industrial Biotechnology Jobs
- Inhibitors
- JAM
- JNU
- Jobs
- Jobs Abroad
- Jobs in Botany
- Jobs in Toxicology
- Jobs in Zoology
- Lab Supplies
- Latest Microbiology Jobs
- Life Sciences Jobs
More
LATEST ARTICLES
Biotecnika Times Newsletter 12.12.2025 – FSSAI 2026 Internship, ARM Scholarship, Govt Tea Board, Pepsi,...
BioTecNika Info Labs Pvt Ltd | Established 2006 | For you
BioTecNika Times
ONLINE | BANGALORE
18 Years of Service dedicated to Bio Professionals & Biotech...
Varun Beverages Ltd Hiring Biotech & Microbiology For Microbiologist Role – Apply on Biotecnika
Microbiologist Job Vacancies at Varun Beverages Ltd
If you’re searching for trusted industry opportunities in the food and beverage sector, the Microbiologist Job Vacancies at...
Naadbramha Idli Hiring Freshers For QC Executive Job – Food Tech & Microbiology Apply...
Freshers QC Executive Jobs at Naadbramha Idli
Job Title: Quality Control Executive
Company Name: Naadbramha Idli
Location: Pune (Pisoli)
Experience: 0–1 Year
CTC: ₹2.5–3 LPA
Preferred Gender: Male
Company Overview
Naadbramha is...
Freshers Biostatistician Jobs For Life Sciences at Inductive Quotient Analytics (IQA), Apply on Biotecnika
Freshers Biostatistician Jobs at Inductive Quotient Analytics (IQA), Apply on Biotecnika
Looking to start your career in clinical data science? Freshers Biostatistician Jobs at Inductive...
Softgel Healthcare BSc Biotech Biotech QA Executive Post – Apply on Biotecnika
BSc Biotech Biotech QA Executive Post - Apply on Biotecnika
If you’re a life science graduate seeking promising quality assurance roles in the biotech industry,...
Softgel Healthcare Hiring BTech Biotech For QA Analyst/Executive Role – Apply on Biotecnika
Biotech QA Analyst/Executive Jobs, Softgel Healthcare Jobs
Professionals looking for stable and rewarding roles in pharmaceutical quality systems will find the latest update on Biotech...
Accures IP Care Hiring Freshers BSc Biotech, Microbiology & Life Sciences For IP Job...
Intellectual Property Jobs For Biotech at Accures IP Care
If you're exploring career opportunities at the intersection of biotechnology and patents, the latest update on...
Absolute Hiring for Freshers R&D Intern Role With Pay – Life Sciences Apply on...
Life Sciences Intern at Absolute - Apply Online
Looking for the perfect start to your biosciences career? The Life Sciences Intern at Absolute - Apply...
Intas Pharma Hiring MSc & BSc Biotech Candidates – Apply on Biotecnika
Intas Pharma Biotech Jobs - Apply on Biotecnika
Looking to grow your career in biotechnology? Intas Pharma Biotech Jobs - Apply on Biotecnika is now...
Intas Pharma Hiring For QC Microbiology Roles – Apply on Biotecnika
Intas Pharma QC Microbiology Roles - Apply on Biotecnika
Company name: Intas Pharmaceuticals
Job Role: QC Microbiology (2-5 yrs)
Location: Ahmedabad
Job Type: Full-Time
Interview Mode: Virtual Walk-in (Two...
Freshers CRA-Medical Device Role at Sascan Meditech Pvt. Ltd. – Biomed Engg & Biotech...
Freshers CRA Job Openings at Sascan Meditech Pvt. Ltd.
If you’re looking to begin your career in clinical research with a strong industry-focused role, the...
FSSAI Internship January 2026 With Rs 10,000/- Stipend | Check Eligibility & Apply Online
FSSAI Internship 2026 January | Govt FSSAI Internship 2026 | Food Tech Internships 2026
Looking to boost your career with top government food safety training?...
Microbiology Jobs At Intas – Attend the Walk-In Interview
Microbiology Jobs | Intas is Hiring | Attend the Virtual Walk-In Interview
If you're looking to accelerate your growth in Microbiology jobs and step into...
Project Associate Jobs – NIPGR Recruitment 2025 Walk-in Interview
Project Associate Jobs – NIPGR Recruitment | Walk-in Interview | Attend Now
The BRIC–National Institute of Plant Genome Research (NIPGR) has announced a new opening...
Assistant Professor Jobs at NFSU | Forensic Science Jobs
Assistant Professor Jobs at NFSU | Forensic Science Jobs | Apply Now
National Forensic Sciences University (NFSU), Dharwad invites highly motivated candidates to apply for...